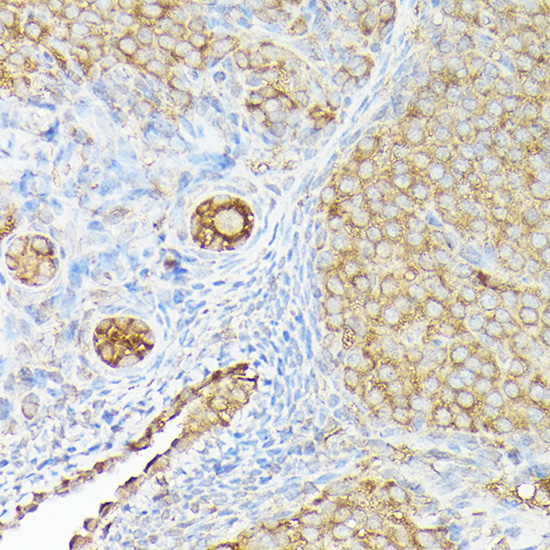

Product Name :CX3CL1 polyclonal antibody
Reactivity :Human, Mouse, Rat
Applications :WB, IHC, IF/ICC
Application_all :WB,1:200 - 1:2000|IHC,1:50 - 1:200|IF/ICC,1:50 - 1:200
Background :This gene belongs to the CX3C subgroup of chemokines, characterized by the number of amino acids located between the conserved cysteine residues. This is the only member of the CX3C subgroup, which contains three amino acids between cysteine residues, resulting in a Cys-X-X-X-Cys configuration. The encoded protein contains an extended mucin-like stalk with a chemokine domain on top, and exists in both a membrane-anchored form where it acts as a binding molecule, or, in soluble form, as a chemotactic cytokine. The mature form of this protein can be cleaved at the cell surface, yielding different soluble forms that can interact with the G-protein coupled receptor, C-X3-C motif chemokine receptor 1 gene product. This gene plays a role in a wide range of diseases, including cancer, vasculitis, neuropathies, atherosclerosis, inflammatory diseases, and in human immunodeficiency virus infections.
Product :1mg/ml in PBS with 0.02% sodium azide, 50% glycerol, pH7.2
Purification&Purity :The antibody was affinity-purified from rabbit antiserum by affinity-chromatography using epitope-specific immunogen and the purity is > 95% (by SDS-PAGE).
Storage&Stability :Store at 4°C short term. Aliquot and store at -20°C long term. Avoid freeze-thaw cycles.
Specificity :Unmodification
Note :For research use only, not for use in diagnostic procedure.
Alternative Name :CX3CL1;ABCD-3;C3Xkine;CXC3;CXC3C;NTN;NTT;SCYD1;fractalkine
Immunogen :Recombinant fusion protein of human CX3CL1(NP_002987.1).
Modification :Unmodification